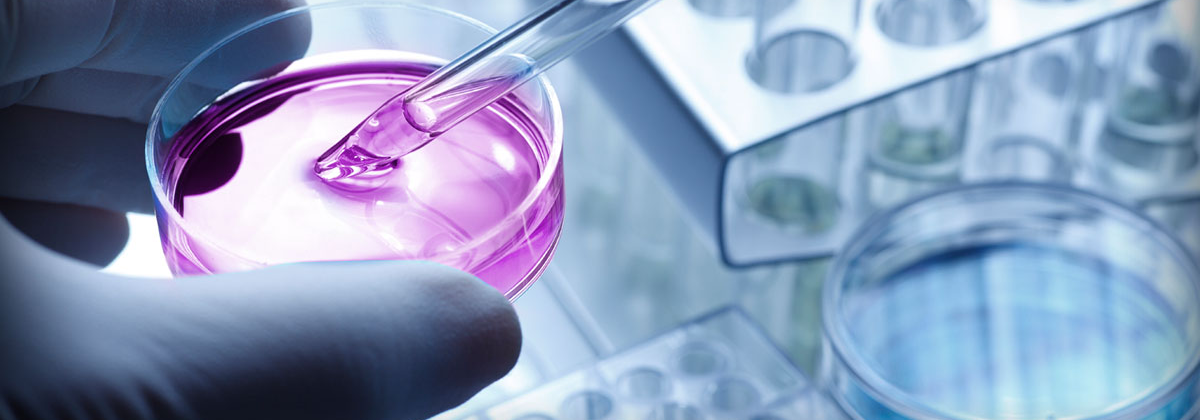

DISTRIBUTORS FOR THE LIFE SAVING PRODUCTS AND SPECIALITIES PRODUCTS IN ONCOLOGY.GASTRO NEPHROLOGY.CARDIAC AND BLOOD PRODUCTS..

NATCO PHARMA LTD.

SANOFI- AVENTIS PHARMA LTD..

PFIZER LTD

DR.REDDY'S PHARMA LTD.

ELI LILLY & CO

CADILA PHARMA LTD.